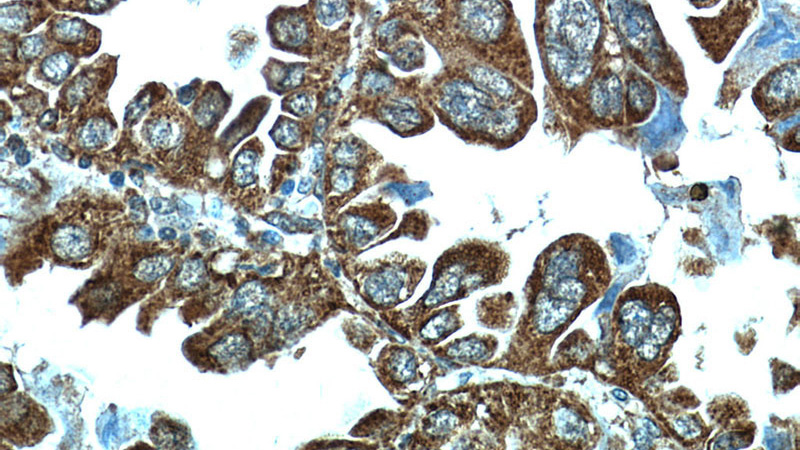
Immunohistochemical of paraffin-embedded human lung cancer using Catalog No:114156(PPPDE1 antibody) at dilution of 1:50 (under 40x lens)

-
Product Name
PPPDE1/PNAS4 antibody
- Documents
-
Description
PPPDE1/PNAS4 Rabbit Polyclonal antibody. Positive WB detected in HeLa cells, A549 cells. Positive IP detected in A549 cells. Positive IHC detected in human lung cancer tissue. Positive IF detected in HepG2 cells. Observed molecular weight by Western-blot: 23 kDa
-
Tested applications
ELISA, WB, IHC, IF, IP
-
Species reactivity
Human,Mouse,Rat; other species not tested.
-
Alternative names
DESI2 antibody; Desumoylating isopeptidase 2 antibody; FAM152A antibody; PNAS 4 antibody; PPPDE1 antibody
-
Isotype
Rabbit IgG
-
Preparation
This antibody was obtained by immunization of PPPDE1/PNAS4 recombinant protein (Accession Number: NM_016076). Purification method: Antigen affinity purified.
-
Clonality
Polyclonal
-
Formulation
PBS with 0.02% sodium azide and 50% glycerol pH 7.3.
-
Storage instructions
Store at -20℃. DO NOT ALIQUOT
-
Applications
Recommended Dilution:
WB: 1:200-1:2000
IP: 1:200-1:2000
IHC: 1:20-1:200
IF: 1:10-1:100
-
Validations

WB result of PPPDE1 antibody (Catalog No:114156, 1:1000) with A549 cells transfected with si-control and si-PPPDE1.

HeLa cells were subjected to SDS PAGE followed by western blot with Catalog No:114156(PPPDE1 antibody) at dilution of 1:500

Immunohistochemical of paraffin-embedded human lung cancer using Catalog No:114156(PPPDE1 antibody) at dilution of 1:50 (under 10x lens)
Immunohistochemical of paraffin-embedded human lung cancer using Catalog No:114156(PPPDE1 antibody) at dilution of 1:50 (under 40x lens)

Immunofluorescent analysis of HepG2 cells, using PPPDE1 antibody Catalog No:114156 at 1:25 dilution and FITC- labeled goat anti-Rabbit IgG (green).

IP Result of anti-PPPDE1 (IP:Catalog No:114156, 4ug; Detection:Catalog No:114156 1:500) with A549 cells lysate 2800ug.
-
Background
PPPDE peptidase domain 1 (PPPDE1), also named as PNAS4, is a highly conserved gene ubiquitously expressed in various tissues. PPPDE1 has been identified as a novel pro-apoptotic gene activated during the early response to DNA damage which is thought to play a critical role in cellular function regarding the maintenance of genomic integrity. This antibody specifically recognized endogenous PPPDE1, which has been confirmed by siRNA test.
-
References
- He Y, Wang J, Gou L. Comprehensive analysis of expression profile reveals the ubiquitous distribution of PPPDE peptidase domain 1, a Golgi apparatus component, and its implications in clinical cancer. Biochimie. 95(7):1466-75. 2013.
- Shen CC, Cui XY, He Y. High Phosphorylation Status of AKT/mTOR Signal in DESI2-Reduced Pancreatic Ductal Adenocarcinoma. Pathology oncology research : POR. 21(2):267-72. 2015.
- Kang YH, Shen CC, Yao YQ. Implications of PPPDE1 expression in the distribution of plakoglobin and β-catenin in pancreatic ductal adenocarcinoma. Oncology letters. 8(3):1229-1233. 2014.
Related Products / Services
Please note: All products are "FOR RESEARCH USE ONLY AND ARE NOT INTENDED FOR DIAGNOSTIC OR THERAPEUTIC USE"
